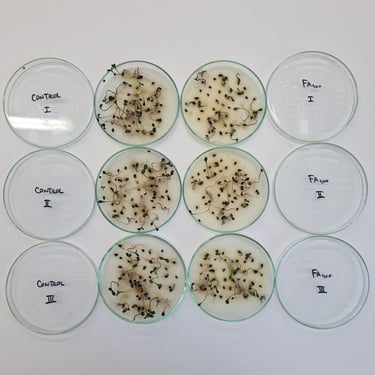

Sustainable Control of Ambrosia artemisiifolia L. with Phenolic Acids
Welcome to the official website of the PHENOMENA project:
Environmental friendly control of Ambrosia artemisiifolia with phenolic acids combined with reduced herbicide dose (IP-2022-10-6639).
Our mission is to develop sustainable and eco-friendly solutions for managing Ambrosia artemisiifolia L., one of the most invasive weeds in agricultural ecosystems. By combining phenolic acids, naturally occurring compounds found in cover crops, with reduced herbicide doses, we aim to achieve more effective and environmentally sustainable weed control, minimizing herbicide use and its ecological footprint while maintaining high control efficacy.
About PHENOMENA
Explore the effects of phenolic acids on the germination and early growth of Ambrosia artemisiifolia, a highly invasive weed species. Learn how these natural compounds could provide sustainable and eco-friendly alternatives to traditional herbicide use.





Gallery
Explore our gallery showcasing the progression of our research project over the years. Here, you will find images of the equipment we've acquired, the experiments we've conducted, and the key results we've achieved.

Contact:
mscepanovic@agr.hr
+38512394033
© 2024. All rights reserved.
